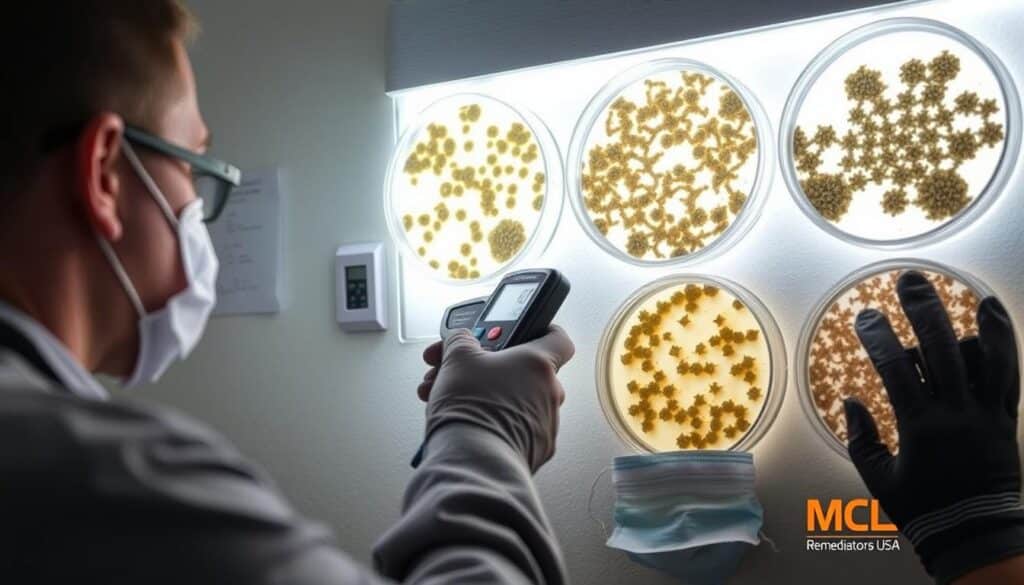
Mold inspection techniques

Did you know mold remediation might be needed if mold covers over 10 square feet? The EPA says this is a key point to remember. As a professional, I’ve learned how important it is to know when to act to keep air quality and health safe.
Mold can cause serious health problems, like allergies and breathing issues. It can even harm the brain, especially for people with weak immune systems. That’s why finding and fixing mold early is so important.
Getting help from mold removal experts, like All Dry, is key. They deal with different mold types, like orange and black. They use special tools and methods to make sure your home is safe.
Key Takeaways
- Mold remediation is necessary when growth exceeds 10 square feet
- Health risks include allergic reactions and respiratory issues
- Professional services are crucial for effective mold removal
- Early detection can significantly reduce remediation costs
- Different mold types require specific remediation strategies
- Proper moisture control is key to preventing mold regrowth
Knowing the signs of mold is important. Look out for water damage, musty smells, and allergies that don’t make sense. If you see these signs, it’s time to get a mold check. This usually costs between $300 and $1,000.
Mold removal is more than just getting rid of visible mold. It involves many steps, like checking, stopping it from spreading, cleaning the air, removing mold, and fixing things up. By acting fast and getting professional help, you protect your home and health.
Understanding Mold and Its Impact on Indoor Environments
Mold is a common problem that harms indoor air quality and health. Mold spores are everywhere, including in our homes. They can grow on any surface with enough moisture. This is why controlling moisture is key to stopping mold.
Types of Mold Commonly Found in Homes
The Centers for Disease Control and Prevention lists the most common indoor molds. These include Cladosporium, Penicillium, Aspergillus, Alternaria, and Stachybotrys chartarum (black mold)4. Each mold type can grow in different parts of your home, affecting air quality.
Health Risks Associated with Mold Exposure
Mold exposure can harm health, especially for those with breathing problems or weak immune systems. Symptoms include nasal congestion, eye irritation, coughing, skin rash, headache, and trouble breathing. Studies show that mold exposure in early life might raise the risk of asthma in children.
The Role of Moisture in Mold Growth
Moisture is essential for mold growth. Moisture sources include roof leaks, plumbing problems, damp basements, and condensation on cool surfaces. Climate change may also lead to more indoor mold due to increased dampness and warmer temperatures.
To keep indoor air quality good and prevent health issues, tackle moisture problems quickly. If you think there’s mold in your home, get help from experts. They can fix the mold and help control moisture.
Identifying Signs of Mold Infestation
As a homeowner, spotting mold early is crucial. Visible mold shows up as fuzzy or slimy stains in various colors on surfaces. I always check for discolored areas on floors, walls, and ceilings during a mold inspection.
Musty odors are another clear sign of mold. If I notice a strong earthy smell, it’s time to investigate. Water damage is a big warning sign, as mold loves damp places. Condensation on windows or walls means moisture issues, which can lead to mold.
Health symptoms can also point to mold problems. If we experience more allergy-like symptoms indoors, like sneezing or skin rashes, it might be mold. In bad cases, mold can make asthma worse or cause respiratory infections.
| Sign | Description | Action |
|---|---|---|
| Visible Mold | Fuzzy or slimy growths on surfaces | Immediate inspection |
| Musty Odors | Persistent earthy smell | Thorough area check |
| Water Damage | Stains or discoloration on surfaces | Address moisture source |
| Health Symptoms | Increased allergic reactions indoors | Consider professional testing |
If I see mold over ten square feet, I call a mold remediation specialist. They can find and remove mold quickly, reducing health risks. Early detection is vital to stop mold from spreading and keep your home safe.
The Importance of Professional Mold Inspections
Professional mold inspections are key to keeping your home healthy. They find mold that you can’t see, hiding in walls or under surfaces.
Visual Inspections vs. Scientific Testing
Visual checks can spot mold, but they’re not enough. The Environmental Protection Agency says experts should do mold testing. Home test kits often give wrong results because of sampling mistakes.
Using Moisture Meters and Thermal Imaging
Experts use special tools like moisture meters and thermal cameras. These tools find where mold might grow because of moisture. Mold loves damp places like bathrooms and basements, making these tools very useful.
The Role of Air Quality Testing in Mold Detection
Air quality tests are a big part of mold inspections. They find mold spores in the air, which can harm your health. Adding mold checks to your home safety routine helps keep your space healthy.
Ignoring mold can harm your health and damage your home. That’s why you should get professional mold inspections for accurate and complete solutions.
When Is Mold Remediation Required?

I’ve learned that mold remediation is needed when mold grows over 10 square feet or is a big health risk. Mold loves warm, humid places, so checking your home often is important. The EPA says you should get professionals for big mold problems, especially after floods or if there’s always moisture.
Seeing mold, damage from water, or a musty smell means you need to act fast. These signs can lead to breathing problems, allergies, and other health issues. The worse the mold and dampness, the bigger the health risks.
Mold can be many colors, from black to gray-green, and can spread spores that make air dirty. Small mold might be fixed with cleaners, but big problems need experts to stop it from spreading and save money.
- Presence of visible mold or water damage
- Mold growth exceeding 10 square feet
- Strong musty odors
- History of flooding or persistent moisture problems
- Health symptoms among occupants
Acting quickly helps control mold and avoid big clean-up jobs. Don’t just paint over mold or use air filters. Fixing the moisture problem, cleaning or removing damaged stuff, and making sure everything is dry and mold-free is key.
The presence of visible mold, moisture, or mold odor in a building is clearly linked to increased respiratory health risks.
Keeping humidity between 30-50% and fixing moisture problems fast can help avoid mold clean-ups. Remember, mold can grow on wood, paper, and insulation, so staying alert is important to stop it.
Factors Influencing the Need for Mold Remediation
I’ve seen how different things can affect if you need mold remediation. Knowing this can help homeowners make smart choices about their home’s health and safety.
Extent of Mold Growth
The size of the mold problem is key in deciding if you need a pro to fix it. Big mold issues need more time and skill to solve. Mold removal can take from 1 to 5 days, based on how bad it is.
Location of Mold in the Property
Where mold grows in your home matters a lot. Mold in places like HVAC systems can spread spores everywhere, making health risks higher. Places like bathrooms, kitchens, and basements are where mold likes to grow because they’re damp and humid.
Underlying Moisture Issues
Fixing the moisture problem is key to stopping mold for good. Water damage from leaks or floods is perfect for mold to grow. Experts do moisture checks to find and fix the moisture that causes mold.
| Factor | Impact on Remediation | Typical Timeframe |
|---|---|---|
| Mold Assessment | Determines extent of problem | 1-2 days |
| Containment Setup | Prevents spread of spores | 1 day |
| Mold Removal | Eliminates visible mold | 1-5 days |
| Cleaning and Sanitizing | Ensures thorough removal | 1-2 days |
| Drying and Dehumidifying | Prevents future growth | 1-3 days |
Good mold remediation is more than just getting rid of visible mold. It’s about fixing the real problems to stop mold from coming back and keep your home healthy. Getting help from pros can be better because they use many methods, from chemicals to natural products.
The Mold Remediation Process: What to Expect
Mold remediation can take one to five days, depending on the situation. Let’s explore what happens during this important process.
The first step is a detailed inspection and air quality check. Experts take samples to understand the problem fully. This helps them plan the best way to remove the mold.
After the assessment, the area is sealed off. This stops mold spores from spreading. It’s key because mold grows fast in damp places.
Then, damaged items are removed. Things like carpeting and drywall are often thrown away. Next, HEPA filters are used to clean the air of spores.
Cleaning the area is very detailed. Experts use special cleaners to kill mold spores. They also use HEPA vacuums to get rid of any leftover mold.
Finally, the area is dried and fixed. This might mean repairing or replacing parts like flooring. The last step is a check to make sure all mold is gone.
“Proper mold remediation is not just about removing visible mold. It’s about addressing the root cause and ensuring a healthy living environment.”
While it might seem like a lot, it’s crucial for your health and home. Professional mold removal ensures everything is done right. This makes your home safer and healthier.
DIY vs. Professional Mold Remediation: Pros and Cons
When I face mold problems, I consider DIY mold removal or professional services. Each has its own benefits and drawbacks. The right choice depends on several factors.
When DIY Methods Are Appropriate
DIY mold removal works for small, surface-level mold issues. It’s cheaper, saving 50% to 75% compared to pros. For minor problems in easy-to-reach spots, a home mold test kit and safety steps can be enough.
Benefits of Professional Mold Remediation Services
Professional services bring expertise, special tools, and thorough treatment. They follow strict standards, ensuring over 90% safety compliance. Many choose pros for their detailed work and cost-effectiveness, especially for big or toxic mold cases.
| Aspect | DIY Mold Removal | Professional Mold Remediation |
|---|---|---|
| Cost | Lower initial cost | Higher upfront cost ($500-$4,000 per project) |
| Effectiveness | Suitable for small areas | Comprehensive for all mold issues |
| Time | Immediate action possible | Scheduled appointments |
| Expertise | Limited knowledge | Years of training and experience |
Risks of Improper Mold Removal
DIY methods often fail, as removing all mold without expert knowledge is hard. Wrong removal can harm health and cause mold to come back. For mold over 100 sq. ft. or in tough spots, getting a pro is best.
The mold remediation market is growing by 5% each year, thanks to more people knowing about mold health risks. This shows how crucial it is to choose wisely when dealing with mold, focusing on safety and effectiveness.
Prevention Strategies: Keeping Mold at Bay
To keep mold away, we need to act early. Understanding what makes mold grow is key. Moisture control, good ventilation, and dehumidification are essential for a mold-free home.
Keeping humidity levels low is critical. I aim to keep humidity under 60% to prevent mold. Using fans and dehumidifiers in damp spots like basements and bathrooms helps a lot.
Regular checks for mold are important. I look for mold signs like spots or patches on walls and floors. Mold can be black, green, white, orange, or pink. A musty smell often means mold is hiding.
Fixing water leaks quickly is crucial. I tackle any plumbing or roof leaks fast to stop moisture buildup. In damp areas, I use materials that resist moisture and apply waterproof sealants.
“An ounce of prevention is worth a pound of cure.”
This saying is very true for mold prevention. By using these strategies, I keep my home healthy and mold-free. This way, I avoid costly clean-ups later.
| Prevention Strategy | Implementation | Benefits |
|---|---|---|
| Moisture Control | Fix leaks, use waterproof sealants | Eliminates mold’s primary growth factor |
| Ventilation | Use exhaust fans, open windows | Reduces humidity, improves air quality |
| Dehumidification | Use dehumidifiers in damp areas | Maintains optimal humidity levels |
Mold prevention is a continuous effort. By being proactive and fixing problems early, I ensure a healthier home for my family and me.
Legal and Insurance Considerations for Mold Remediation
Dealing with mold insurance can be complex. Most home policies cover mold from sudden water damage, like burst pipes. But they don’t cover damage from neglect or flooding. It’s important to check your policy’s details.
Mold coverage limits vary, usually between $1,000 to $10,000. Some insurers offer extra endorsements for more protection. If mold worries you, talk to your insurance about these options.
Liability is also a big deal. As a homeowner, you must keep your property safe from mold. Quick action on leaks and regular care are key. If you ignore mold, you might have to pay for removal.
Keeping records is vital for mold claims. I suggest documenting any water damage, maintenance, and mold findings. This info is crucial for claims or legal battles.
There are no federal mold remediation standards. If mold covers more than 10 square feet, it’s a Mold Project needing a pro’s check. In such cases, hiring experts is not just wise – it’s often required by law.
Mold remediation can lead to big legal and financial problems. Always get advice from insurance and legal experts to protect yourself.
Choosing a Qualified Mold Remediation Company
Finding the right mold remediation company is key for your health and home. Mold can be dangerous, so it’s vital to pick experts who can handle it safely and well.
Certifications and Qualifications to Look For
Look for a certified mold remediator with certifications from groups like the Institute of Inspection, Cleaning, and Restoration Certification (IICRC) or the Indoor Air Quality Association (IAQA). These show the company meets high standards, like the IICRC S520 Standard for mold remediation.
Experience is also important. A company with lots of experience in home mold removal knows how to solve many problems. Make sure they are licensed and insured to protect you from risks.
Questions to Ask Before Hiring a Mold Remediator
Ask about their testing methods first. A good company will test mold samples to find the right removal methods. Also, ask about their safety measures, like protective gear and how they dispose of mold.
Ask for a detailed plan of their work, including what products they’ll use. It’s smart to ask about services after the job, like re-testing and proof of no mold.
Understanding Mold Remediation Estimates
A good estimate should explain what they’ll do, what tools they’ll use, and how long it will take. Be careful of very low prices, as they might not solve the mold problem fully.
For mold over 10 square feet in your home, the EPA says you need professional help. By picking a qualified company and knowing their process, you’re making your home safer from mold.
Conclusion
Mold prevention and professional mold remediation are key to a healthy home. Mold thrives in humid places, like Florida, where floods and leaks are common. It’s important to get rid of mold to keep our homes safe and healthy.
Mold not only harms buildings but also releases spores that can make us sick. These spores can cause wheezing, coughing, and asthma-like symptoms. People with breathing issues or allergies may get even sicker, with skin and eye problems.
Experts in mold remediation have the skills and tools to handle big problems safely. They check for mold, stop spores, clean up, and prevent future problem. Knowing the signs of mold and controlling moisture helps protect our homes and health. Keeping an eye on things and acting fast is crucial for clean air inside.
FAQ
When is mold remediation required?
Mold remediation is needed when mold harms indoor air and health. The EPA suggests hiring pros for big mold issues over 10 square feet. It’s also key when mold risks people’s health.
What are the different types of mold commonly found in homes?
Homes often have orange, white, and black mold. Orange mold is slimy, white can damage buildings, and black mold is very dangerous.
What are some signs of mold infestation?
Mold signs include visible growth, musty smells, and water damage. You need to check carefully for mold behind walls or under floors.
Why are professional mold inspections important?
Pro inspections use eyes and science like moisture meters and air tests. They find mold accurately and guide how to fix it.
What factors influence the need for mold remediation?
Mold removal needs depend on how much mold there is, where it is, and moisture levels. Big mold, mold in important places, and constant moisture need experts.
What does the mold remediation process involve?
The process includes sealing off the area, using negative air pressure, and HEPA filters. Safe cleaners are used to remove mold. Then, moisture sources are fixed and everything is documented.
When are DIY methods appropriate for mold removal?
DIY works for small, surface mold. But, pros have the right tools and know-how for big or complex mold jobs.
What are some effective mold prevention strategies?
To stop mold, control moisture, ensure air flow, and use dehumidifiers. Regular checks, fixing leaks fast, and keeping humidity below 60% help too.
What legal and insurance considerations are involved in mold remediation?
Legal and insurance matters include knowing what’s covered, liability, and the need for detailed records. Some policies limit mold coverage, so it’s important to check your policy.
What should I look for when choosing a mold remediation company?
Look for companies that follow IICRC S520 standards. Check their experience, methods, safety, and understand the cost and timeline of the job.



